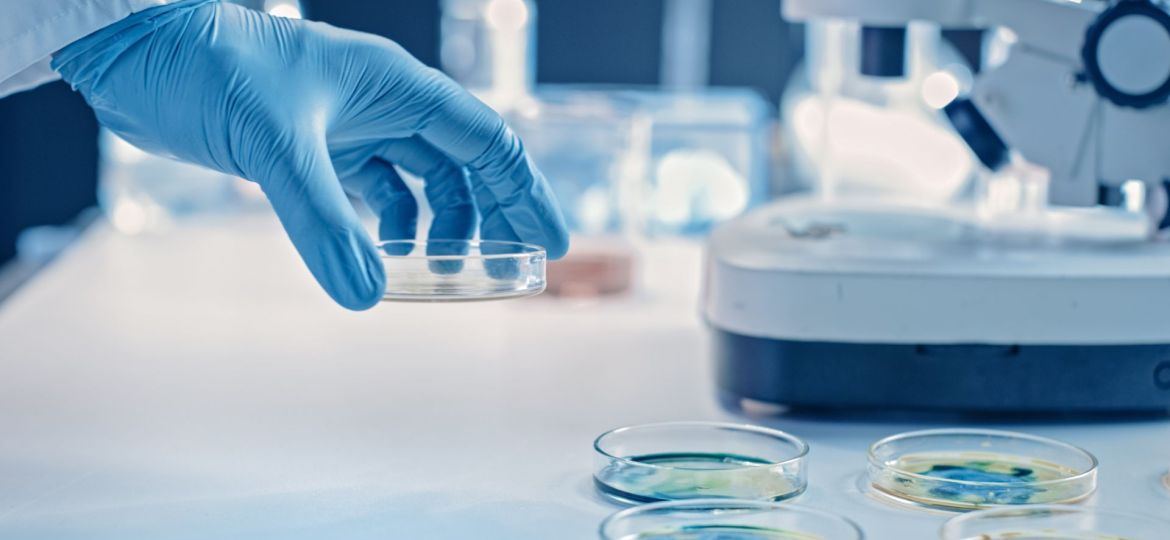

O cancro do pâncreas é um dos mais difíceis de tratar e com uma das tarefas de sobrevivência mais baixas: apenas 10% ao fim de cinco anos. Agora, um novo estudo lança luz sobre o que pode ser responsável pela agressividade deste tipo de cancro.
O cancro do pâncreas é um dos cancros mais agressivos e um dos fatores que contribui para a sua agressividade é o microambiente tumoral, conhecido como estroma, que constitui a maior parte da massa tumoral e consiste numa rede de proteínas e diferentes células não tumorais. Entre estas estão os fibroblastos, que desempenham um papel fundamental, ajudando as células tumorais a crescer e aumentando a sua resistência aos medicamentos.
Agora, um estudo liderado por investigadores do Instituto de Investigação do Hospital del Mar, IIBB-CSIC-IDIBAPS, Clínica Mayo, Instituto de Biologia y Medicina Experimental (CONICET, Argentina) e Instituto CaixaResearch, identificou um novo fator que contribui para esta característica do cancro do pâncreas: uma função até então desconhecida de uma proteína, conhecida como Galectina-1, dentro do núcleo dos fibroblastos.
Esta descoberta, publicada na revista PNAS, oferece novos conhecimentos sobre o papel destas células no desenvolvimento do cancro do pâncreas e abre portas a novas estratégias de tratamento contra este tipo de tumor, com foco na possibilidade de inibir esta proteína dentro das células que o envolvem e protegem.
“O estroma é considerado um componente chave na agressividade do cancro do pâncreas, uma vez que interage com as células tumorais, protegendo-as e impedindo a ação dos medicamentos. Além disso, as células estromais, sobretudo os fibroblastos, produzem substâncias que favorecem o crescimento e a disseminação do tumor”, explica Pilar Navarro, coordenadora do Grupo de Investigação em Alvos Moleculares do Cancro do Instituto de Investigação do Hospital del Mar e do IIBB-CSIC-IDIBAPS.
Até agora, sabia-se que os fibroblastos segregavam Galectina-1, uma proteína com propriedades pró-tumorais. Este estudo, no entanto, mostra que a molécula também se localiza dentro dos fibroblastos, especificamente nos seus núcleos, onde desempenha um papel fundamental na regulação da expressão genética.
A presença desta molécula ativa os fibroblastos, fazendo com que estes permitam o desenvolvimento das células tumorais. Os investigadores descobriram ainda que “a galectina-1 pode regular a expressão genética nestas células a um nível altamente específico, sem alterar a sequência de ADN, através do controlo epigenético. Um dos genes que regula é o KRAS, que desempenha um papel crítico nos tumores pancreáticos”, explica Navarro.
Este gene está também presente nas células tumorais em 90% dos doentes, embora neste caso esteja mutado. É considerado um dos principais causadores do crescimento descontrolado e da agressividade tumoral.
Desenhar novas estratégias para o cancro do pâncreas
A equipa por detrás do estudo já tinha identificado o papel importante da Galectina-1 no cancro do pâncreas. No entanto, as funções recentemente descobertas abrem agora caminho para o desenvolvimento de novas estratégias para combater este tipo de tumores.
“Até agora, os esforços têm-se concentrado na inibição da Galectina-1 segregada pelo estroma que rodeia o tumor. Mas vemos que também precisamos de bloquear a proteína dentro do núcleo do fibroblasto”, afirma Neus Martínez-Bosch, investigador do Instituto de Investigação do Hospital del Mar. “Precisamos de encontrar novos inibidores que atuem dentro dos fibroblastos, não apenas sobre a proteína que segregam”, acrescenta.
Judith Vinaixa, também investigadora do Instituto de Investigação do Hospital del Mar e primeira autora do estudo, realça a importância destes resultados: “confirmamos o papel fundamental da Galectina-1 no núcleo das células dos fibroblastos no cancro do pâncreas, onde regula a expressão de múltiplos genes essenciais para o comportamento celular”.
Gabriel Rabinovich, investigador do IBYME (CONICET) e do Instituto CaixaResearch, acrescenta que “os próximos passos passarão pela exploração de combinações terapêuticas que inibam a Galectina-1 tanto extracelular como intracelular. Esta proteína também participa em processos-chave, como a formação de vasos sanguíneos e a resistência à imunoterapia. Portanto, esta estratégia torna-se particularmente relevante, dados os múltiplos efeitos antitumorais da inibição da Galectina-1”.















